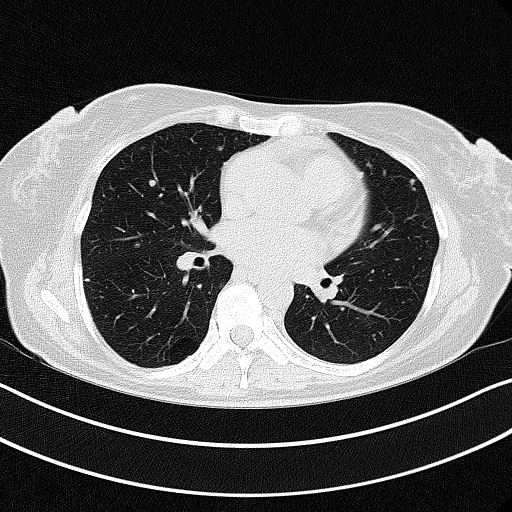
Original NATIVE CT scan (input)

GAN Medical CT Evaluation Report
Patient: PN17122020
Slice 70 Targeting Evaluation
Patient Information
Patient ID: PN17122020
Model: cytran
Slice: Slice_70
Slice Thickness: 3.0mm
Conversion: NATIVE → VENOUS
📊 Download Metrics
📥 Download CSV Metrics (patient_PN17122020_metrics.csv)Contains all 4 metric datasets: Network-Normalized, Hounsfield Units, Lung Window, and Mediastinum Window
Native→Venous Translation Metrics (Generated Venous vs Real Venous)
Targeted Slice 70 - Network-Normalized Analysis (Generated vs Real Venous)
0.828
SSIM Score
0.120
RMSE
0.061
MAE
Average Network-Normalized Metrics Across All Slices (153 slices) - Generated vs Real Venous
0.828
SSIM Score (Avg)
0.125
RMSE (Avg)
0.060
MAE (Avg)
Targeted Slice 70 - HU-Space Analysis (Generated vs Real Venous)
0.828
HU SSIM
120.0
HU RMSE
60.9
HU MAE
Average HU-Space Metrics Across All Slices (153 slices) - Generated vs Real Venous
0.829
HU SSIM (Avg)
124.1
HU RMSE (Avg)
59.1
HU MAE (Avg)
Targeted Slice 70 - Lung Window Analysis (Generated vs Real Venous)
0.680
Lung SSIM
103.5
Lung RMSE
52.1
Lung MAE
Average Lung Window Metrics Across All Slices (153 slices) - Generated vs Real Venous
0.686
Lung SSIM (Avg)
108.5
Lung RMSE (Avg)
51.4
Lung MAE (Avg)
Targeted Slice 70 - Mediastinum Window Analysis (Generated vs Real Venous)
0.679
Mediastinum SSIM
51.7
Mediastinum RMSE
22.6
Mediastinum MAE
Average Mediastinum Window Metrics Across All Slices (153 slices) - Generated vs Real Venous
0.674
Mediastinum SSIM (Avg)
52.0
Mediastinum RMSE (Avg)
22.7
Mediastinum MAE (Avg)
Detailed Per-Slice Metrics
| Slice ID | SSIM | RMSE | MAE | HU SSIM | HU RMSE | HU MAE | Lung SSIM | Lung RMSE | Lung MAE | Mediastinum SSIM | Mediastinum RMSE | Mediastinum MAE |
|---|---|---|---|---|---|---|---|---|---|---|---|---|
| PN17122020_slice_0 | 0.846 | 0.103 | 0.045 | 0.846 | 102.7 | 44.6 | 0.745 | 62.9 | 31.3 | 0.668 | 49.3 | 21.6 |
| PN17122020_slice_1 | 0.841 | 0.101 | 0.046 | 0.841 | 101.2 | 45.4 | 0.738 | 64.1 | 32.4 | 0.664 | 50.0 | 22.0 |
| PN17122020_slice_2 | 0.835 | 0.105 | 0.047 | 0.836 | 104.6 | 47.2 | 0.731 | 67.9 | 34.1 | 0.660 | 50.5 | 22.5 |
| PN17122020_slice_3 | 0.832 | 0.106 | 0.048 | 0.833 | 105.5 | 48.1 | 0.725 | 69.7 | 34.9 | 0.656 | 50.8 | 22.6 |
| PN17122020_slice_4 | 0.833 | 0.106 | 0.049 | 0.833 | 105.4 | 48.5 | 0.723 | 68.6 | 35.2 | 0.657 | 51.0 | 22.7 |
| PN17122020_slice_5 | 0.825 | 0.106 | 0.049 | 0.826 | 105.8 | 49.1 | 0.721 | 69.1 | 36.0 | 0.659 | 53.3 | 23.5 |
| PN17122020_slice_6 | 0.820 | 0.109 | 0.051 | 0.820 | 109.3 | 50.3 | 0.719 | 74.7 | 36.9 | 0.657 | 52.6 | 23.3 |
| PN17122020_slice_7 | 0.822 | 0.115 | 0.052 | 0.822 | 115.1 | 52.0 | 0.721 | 80.7 | 38.1 | 0.657 | 51.7 | 22.8 |
| PN17122020_slice_8 | 0.815 | 0.123 | 0.055 | 0.815 | 122.6 | 54.6 | 0.714 | 88.5 | 40.5 | 0.654 | 54.2 | 23.5 |
| PN17122020_slice_9 | 0.819 | 0.126 | 0.055 | 0.819 | 125.9 | 55.3 | 0.714 | 93.4 | 41.6 | 0.654 | 54.7 | 23.6 |
| PN17122020_slice_10 | 0.822 | 0.126 | 0.056 | 0.822 | 126.2 | 55.6 | 0.715 | 94.7 | 42.3 | 0.652 | 55.5 | 23.8 |
| PN17122020_slice_11 | 0.824 | 0.122 | 0.054 | 0.824 | 122.0 | 54.3 | 0.717 | 90.8 | 41.3 | 0.656 | 55.3 | 23.5 |
| PN17122020_slice_12 | 0.834 | 0.116 | 0.052 | 0.834 | 115.9 | 51.7 | 0.727 | 84.8 | 39.2 | 0.669 | 52.6 | 22.2 |
| PN17122020_slice_13 | 0.842 | 0.113 | 0.050 | 0.842 | 112.8 | 50.3 | 0.733 | 81.5 | 38.3 | 0.677 | 50.4 | 21.1 |
| PN17122020_slice_14 | 0.848 | 0.110 | 0.050 | 0.848 | 109.7 | 49.4 | 0.738 | 78.7 | 37.7 | 0.683 | 49.1 | 20.6 |
| PN17122020_slice_15 | 0.845 | 0.111 | 0.051 | 0.845 | 110.6 | 50.5 | 0.736 | 79.2 | 38.4 | 0.688 | 49.7 | 20.8 |
| PN17122020_slice_16 | 0.843 | 0.114 | 0.053 | 0.843 | 114.1 | 52.4 | 0.734 | 81.6 | 39.8 | 0.688 | 50.7 | 21.0 |
| PN17122020_slice_17 | 0.849 | 0.112 | 0.052 | 0.849 | 112.3 | 51.6 | 0.740 | 80.7 | 39.7 | 0.691 | 49.2 | 20.3 |
| PN17122020_slice_18 | 0.856 | 0.108 | 0.049 | 0.857 | 108.1 | 49.3 | 0.746 | 79.7 | 38.5 | 0.695 | 46.9 | 19.2 |
| PN17122020_slice_19 | 0.856 | 0.105 | 0.049 | 0.857 | 104.4 | 48.5 | 0.742 | 80.0 | 38.7 | 0.695 | 47.1 | 19.4 |
| PN17122020_slice_20 | 0.860 | 0.102 | 0.048 | 0.861 | 101.7 | 47.9 | 0.744 | 79.1 | 38.8 | 0.701 | 46.5 | 19.2 |
| PN17122020_slice_21 | 0.859 | 0.102 | 0.048 | 0.859 | 102.2 | 48.1 | 0.742 | 79.0 | 38.9 | 0.701 | 47.4 | 19.5 |
| PN17122020_slice_22 | 0.861 | 0.101 | 0.048 | 0.861 | 100.9 | 47.5 | 0.742 | 78.4 | 38.7 | 0.705 | 46.5 | 19.0 |
| PN17122020_slice_23 | 0.866 | 0.097 | 0.046 | 0.867 | 96.8 | 46.1 | 0.748 | 75.3 | 37.5 | 0.717 | 43.9 | 17.9 |
| PN17122020_slice_24 | 0.870 | 0.096 | 0.046 | 0.871 | 95.7 | 45.5 | 0.753 | 73.5 | 36.7 | 0.722 | 42.7 | 17.2 |
| PN17122020_slice_25 | 0.870 | 0.097 | 0.046 | 0.871 | 97.3 | 45.9 | 0.753 | 73.5 | 36.8 | 0.724 | 42.7 | 17.1 |
| PN17122020_slice_26 | 0.873 | 0.097 | 0.046 | 0.873 | 96.9 | 46.2 | 0.759 | 73.1 | 37.2 | 0.727 | 43.2 | 17.0 |
| PN17122020_slice_27 | 0.870 | 0.098 | 0.047 | 0.870 | 97.7 | 47.3 | 0.755 | 74.7 | 38.5 | 0.728 | 43.8 | 17.3 |
| PN17122020_slice_28 | 0.865 | 0.096 | 0.049 | 0.865 | 96.2 | 48.3 | 0.746 | 76.1 | 40.1 | 0.721 | 44.4 | 18.0 |
| PN17122020_slice_29 | 0.866 | 0.094 | 0.048 | 0.867 | 93.6 | 47.9 | 0.746 | 75.9 | 40.4 | 0.724 | 44.2 | 17.9 |
| PN17122020_slice_30 | 0.870 | 0.095 | 0.048 | 0.871 | 94.8 | 47.8 | 0.749 | 76.0 | 40.4 | 0.727 | 43.3 | 17.5 |
| PN17122020_slice_31 | 0.872 | 0.095 | 0.048 | 0.872 | 95.0 | 47.8 | 0.748 | 77.5 | 40.8 | 0.726 | 43.3 | 17.5 |
| PN17122020_slice_32 | 0.874 | 0.094 | 0.048 | 0.875 | 93.5 | 47.7 | 0.750 | 75.4 | 40.4 | 0.727 | 43.3 | 17.6 |
| PN17122020_slice_33 | 0.876 | 0.092 | 0.047 | 0.876 | 91.7 | 47.2 | 0.749 | 73.8 | 39.8 | 0.727 | 42.8 | 17.4 |
| PN17122020_slice_34 | 0.877 | 0.094 | 0.048 | 0.877 | 93.7 | 47.6 | 0.748 | 73.7 | 39.8 | 0.733 | 42.6 | 17.1 |
| PN17122020_slice_35 | 0.880 | 0.094 | 0.048 | 0.881 | 94.2 | 47.6 | 0.755 | 72.6 | 39.2 | 0.739 | 41.9 | 16.7 |
| PN17122020_slice_36 | 0.880 | 0.094 | 0.049 | 0.880 | 93.8 | 48.3 | 0.751 | 73.1 | 40.2 | 0.737 | 42.7 | 17.0 |
| PN17122020_slice_37 | 0.874 | 0.098 | 0.051 | 0.874 | 97.4 | 50.4 | 0.743 | 75.6 | 42.1 | 0.731 | 44.1 | 17.9 |
| PN17122020_slice_38 | 0.872 | 0.097 | 0.051 | 0.873 | 96.7 | 50.9 | 0.739 | 77.1 | 43.0 | 0.729 | 45.2 | 18.4 |
| PN17122020_slice_39 | 0.872 | 0.095 | 0.051 | 0.872 | 94.7 | 50.3 | 0.735 | 77.2 | 43.1 | 0.727 | 44.8 | 18.4 |
| PN17122020_slice_40 | 0.869 | 0.093 | 0.050 | 0.869 | 93.2 | 50.0 | 0.728 | 77.9 | 43.4 | 0.724 | 43.9 | 18.5 |
| PN17122020_slice_41 | 0.868 | 0.093 | 0.050 | 0.869 | 92.2 | 49.7 | 0.728 | 79.6 | 43.7 | 0.724 | 43.8 | 18.4 |
| PN17122020_slice_42 | 0.870 | 0.095 | 0.050 | 0.870 | 94.7 | 49.8 | 0.729 | 80.2 | 43.4 | 0.726 | 45.3 | 18.6 |
| PN17122020_slice_43 | 0.866 | 0.101 | 0.051 | 0.866 | 101.2 | 51.1 | 0.722 | 83.0 | 43.9 | 0.723 | 46.3 | 19.0 |
| PN17122020_slice_44 | 0.866 | 0.102 | 0.051 | 0.867 | 102.0 | 50.8 | 0.726 | 83.2 | 43.2 | 0.725 | 44.8 | 18.3 |
| PN17122020_slice_45 | 0.865 | 0.102 | 0.051 | 0.865 | 102.1 | 50.9 | 0.725 | 82.2 | 42.7 | 0.726 | 44.7 | 18.2 |
| PN17122020_slice_46 | 0.865 | 0.101 | 0.051 | 0.865 | 100.6 | 51.2 | 0.722 | 81.5 | 42.9 | 0.726 | 43.9 | 18.0 |
| PN17122020_slice_47 | 0.865 | 0.100 | 0.052 | 0.865 | 99.3 | 51.5 | 0.726 | 79.1 | 42.9 | 0.730 | 43.1 | 17.9 |
| PN17122020_slice_48 | 0.862 | 0.102 | 0.053 | 0.862 | 101.8 | 52.8 | 0.723 | 78.3 | 43.7 | 0.724 | 45.3 | 18.8 |
| PN17122020_slice_49 | 0.858 | 0.103 | 0.055 | 0.859 | 102.6 | 54.4 | 0.715 | 80.9 | 45.5 | 0.720 | 47.5 | 19.6 |
| PN17122020_slice_50 | 0.860 | 0.100 | 0.055 | 0.861 | 99.5 | 54.5 | 0.716 | 82.1 | 46.8 | 0.721 | 46.9 | 19.6 |
| PN17122020_slice_51 | 0.862 | 0.098 | 0.055 | 0.862 | 98.0 | 54.3 | 0.716 | 82.2 | 47.1 | 0.721 | 46.1 | 19.3 |
| PN17122020_slice_52 | 0.861 | 0.097 | 0.054 | 0.862 | 96.9 | 53.9 | 0.716 | 83.7 | 47.2 | 0.719 | 45.1 | 19.1 |
| PN17122020_slice_53 | 0.862 | 0.096 | 0.053 | 0.863 | 95.3 | 53.1 | 0.719 | 83.3 | 46.7 | 0.718 | 45.9 | 19.5 |
| PN17122020_slice_54 | 0.860 | 0.097 | 0.054 | 0.861 | 96.6 | 53.3 | 0.715 | 82.9 | 46.6 | 0.716 | 47.1 | 20.1 |
| PN17122020_slice_55 | 0.858 | 0.101 | 0.055 | 0.859 | 100.5 | 54.6 | 0.713 | 82.6 | 46.7 | 0.712 | 48.6 | 20.6 |
| PN17122020_slice_56 | 0.857 | 0.103 | 0.055 | 0.857 | 102.2 | 54.8 | 0.714 | 81.5 | 46.2 | 0.712 | 49.0 | 20.7 |
| PN17122020_slice_57 | 0.854 | 0.103 | 0.056 | 0.855 | 102.6 | 55.3 | 0.710 | 81.9 | 46.5 | 0.714 | 48.1 | 20.4 |
| PN17122020_slice_58 | 0.856 | 0.103 | 0.056 | 0.856 | 102.2 | 56.0 | 0.707 | 82.9 | 47.3 | 0.714 | 48.0 | 20.4 |
| PN17122020_slice_59 | 0.856 | 0.102 | 0.056 | 0.857 | 101.4 | 55.5 | 0.713 | 82.9 | 46.7 | 0.717 | 47.7 | 20.4 |
| PN17122020_slice_60 | 0.855 | 0.104 | 0.057 | 0.855 | 103.9 | 56.2 | 0.711 | 83.2 | 46.8 | 0.712 | 47.4 | 20.4 |
| PN17122020_slice_61 | 0.848 | 0.110 | 0.059 | 0.849 | 109.1 | 58.3 | 0.699 | 86.6 | 48.8 | 0.702 | 50.3 | 21.4 |
| PN17122020_slice_62 | 0.842 | 0.111 | 0.060 | 0.843 | 110.1 | 58.9 | 0.690 | 90.9 | 50.2 | 0.692 | 50.9 | 21.7 |
| PN17122020_slice_63 | 0.836 | 0.111 | 0.059 | 0.837 | 110.5 | 58.7 | 0.679 | 94.9 | 50.9 | 0.686 | 50.4 | 21.7 |
| PN17122020_slice_64 | 0.832 | 0.113 | 0.060 | 0.833 | 112.4 | 59.1 | 0.674 | 99.6 | 52.1 | 0.679 | 50.1 | 21.7 |
| PN17122020_slice_65 | 0.836 | 0.112 | 0.058 | 0.836 | 112.0 | 57.7 | 0.680 | 100.8 | 51.0 | 0.682 | 48.2 | 21.0 |
| PN17122020_slice_66 | 0.838 | 0.114 | 0.058 | 0.838 | 113.2 | 57.7 | 0.686 | 102.5 | 51.1 | 0.684 | 48.6 | 21.0 |
| PN17122020_slice_67 | 0.833 | 0.118 | 0.060 | 0.834 | 117.7 | 60.0 | 0.682 | 104.8 | 52.5 | 0.679 | 51.2 | 22.0 |
| PN17122020_slice_68 | 0.833 | 0.119 | 0.060 | 0.833 | 119.1 | 59.7 | 0.684 | 104.2 | 51.8 | 0.680 | 50.6 | 21.9 |
| PN17122020_slice_69 | 0.832 | 0.119 | 0.060 | 0.832 | 118.4 | 59.7 | 0.686 | 103.2 | 51.6 | 0.682 | 50.1 | 21.9 |
| PN17122020_slice_70 | 0.828 | 0.120 | 0.061 | 0.828 | 120.0 | 60.9 | 0.680 | 103.5 | 52.1 | 0.679 | 51.7 | 22.6 |
| PN17122020_slice_71 | 0.826 | 0.121 | 0.062 | 0.827 | 120.8 | 61.6 | 0.678 | 105.3 | 52.6 | 0.679 | 51.4 | 22.7 |
| PN17122020_slice_72 | 0.827 | 0.124 | 0.063 | 0.828 | 123.3 | 62.8 | 0.677 | 107.9 | 53.8 | 0.676 | 51.1 | 22.4 |
| PN17122020_slice_73 | 0.820 | 0.130 | 0.067 | 0.821 | 129.0 | 66.1 | 0.666 | 112.7 | 57.4 | 0.672 | 53.8 | 23.4 |
| PN17122020_slice_74 | 0.814 | 0.131 | 0.068 | 0.815 | 129.9 | 66.9 | 0.661 | 115.5 | 58.6 | 0.666 | 53.8 | 23.5 |
| PN17122020_slice_75 | 0.814 | 0.130 | 0.066 | 0.815 | 129.6 | 65.7 | 0.656 | 115.0 | 57.5 | 0.660 | 52.5 | 23.2 |
| PN17122020_slice_76 | 0.814 | 0.128 | 0.065 | 0.815 | 128.0 | 64.3 | 0.655 | 114.9 | 56.8 | 0.659 | 53.4 | 23.6 |
| PN17122020_slice_77 | 0.817 | 0.126 | 0.063 | 0.817 | 125.3 | 62.6 | 0.659 | 113.0 | 55.4 | 0.658 | 52.9 | 23.6 |
| PN17122020_slice_78 | 0.817 | 0.126 | 0.063 | 0.818 | 125.4 | 62.4 | 0.660 | 112.7 | 54.9 | 0.662 | 53.5 | 23.8 |
| PN17122020_slice_79 | 0.814 | 0.128 | 0.064 | 0.815 | 127.8 | 63.4 | 0.656 | 114.3 | 55.5 | 0.660 | 54.4 | 24.3 |
| PN17122020_slice_80 | 0.817 | 0.128 | 0.063 | 0.818 | 127.9 | 62.3 | 0.660 | 114.5 | 54.5 | 0.664 | 53.3 | 23.6 |
| PN17122020_slice_81 | 0.814 | 0.131 | 0.064 | 0.815 | 130.4 | 63.4 | 0.659 | 116.3 | 55.3 | 0.667 | 54.4 | 24.0 |
| PN17122020_slice_82 | 0.809 | 0.133 | 0.065 | 0.809 | 133.0 | 64.9 | 0.654 | 118.2 | 56.1 | 0.662 | 55.2 | 24.6 |
| PN17122020_slice_83 | 0.807 | 0.134 | 0.066 | 0.808 | 133.8 | 65.6 | 0.649 | 119.4 | 57.1 | 0.660 | 54.8 | 24.2 |
| PN17122020_slice_84 | 0.802 | 0.137 | 0.067 | 0.804 | 136.2 | 66.7 | 0.641 | 121.0 | 57.8 | 0.658 | 54.4 | 23.9 |
| PN17122020_slice_85 | 0.800 | 0.139 | 0.068 | 0.801 | 138.0 | 67.7 | 0.638 | 120.8 | 58.3 | 0.661 | 55.7 | 24.3 |
| PN17122020_slice_86 | 0.803 | 0.136 | 0.067 | 0.804 | 135.9 | 66.7 | 0.643 | 119.9 | 57.7 | 0.662 | 54.8 | 23.9 |
| PN17122020_slice_87 | 0.802 | 0.136 | 0.067 | 0.803 | 135.3 | 66.5 | 0.641 | 121.8 | 58.1 | 0.665 | 54.1 | 23.5 |
| PN17122020_slice_88 | 0.799 | 0.138 | 0.068 | 0.800 | 137.3 | 67.4 | 0.638 | 124.1 | 59.3 | 0.667 | 53.9 | 23.4 |
| PN17122020_slice_89 | 0.800 | 0.138 | 0.068 | 0.801 | 137.1 | 67.3 | 0.642 | 125.1 | 59.7 | 0.673 | 53.8 | 23.2 |
| PN17122020_slice_90 | 0.800 | 0.138 | 0.068 | 0.801 | 137.1 | 67.3 | 0.641 | 124.5 | 59.5 | 0.680 | 53.8 | 23.2 |
| PN17122020_slice_91 | 0.796 | 0.138 | 0.067 | 0.797 | 137.5 | 67.1 | 0.635 | 124.6 | 59.2 | 0.684 | 53.7 | 23.2 |
| PN17122020_slice_92 | 0.792 | 0.140 | 0.068 | 0.793 | 139.1 | 67.1 | 0.628 | 125.6 | 59.2 | 0.683 | 53.9 | 22.9 |
| PN17122020_slice_93 | 0.793 | 0.140 | 0.068 | 0.794 | 139.0 | 67.2 | 0.629 | 125.3 | 58.8 | 0.690 | 54.0 | 22.8 |
| PN17122020_slice_94 | 0.791 | 0.141 | 0.069 | 0.792 | 140.6 | 68.6 | 0.630 | 126.3 | 59.7 | 0.690 | 54.1 | 22.8 |
| PN17122020_slice_95 | 0.793 | 0.143 | 0.071 | 0.795 | 142.1 | 69.8 | 0.638 | 127.8 | 61.2 | 0.690 | 54.1 | 22.6 |
| PN17122020_slice_96 | 0.793 | 0.145 | 0.071 | 0.794 | 144.0 | 70.2 | 0.637 | 129.8 | 61.9 | 0.694 | 54.4 | 22.6 |
| PN17122020_slice_97 | 0.790 | 0.146 | 0.071 | 0.792 | 145.2 | 70.6 | 0.641 | 131.5 | 62.6 | 0.696 | 55.1 | 22.9 |
| PN17122020_slice_98 | 0.794 | 0.149 | 0.072 | 0.795 | 148.0 | 71.2 | 0.643 | 135.0 | 63.4 | 0.697 | 54.8 | 22.5 |
| PN17122020_slice_99 | 0.796 | 0.151 | 0.072 | 0.797 | 150.0 | 70.9 | 0.643 | 137.7 | 63.3 | 0.697 | 55.2 | 22.3 |
| PN17122020_slice_100 | 0.800 | 0.151 | 0.070 | 0.802 | 149.9 | 69.5 | 0.650 | 137.8 | 62.4 | 0.701 | 54.4 | 21.8 |
| PN17122020_slice_101 | 0.803 | 0.151 | 0.069 | 0.805 | 149.7 | 67.9 | 0.656 | 139.2 | 61.3 | 0.704 | 53.4 | 21.2 |
| PN17122020_slice_102 | 0.804 | 0.151 | 0.068 | 0.805 | 150.0 | 67.3 | 0.659 | 140.6 | 60.8 | 0.707 | 52.7 | 20.9 |
| PN17122020_slice_103 | 0.801 | 0.156 | 0.070 | 0.802 | 154.2 | 68.9 | 0.655 | 145.2 | 62.7 | 0.705 | 52.7 | 20.9 |
| PN17122020_slice_104 | 0.798 | 0.158 | 0.071 | 0.800 | 156.9 | 70.0 | 0.653 | 148.8 | 64.2 | 0.703 | 53.2 | 21.1 |
| PN17122020_slice_105 | 0.800 | 0.159 | 0.071 | 0.802 | 157.4 | 70.1 | 0.654 | 148.9 | 64.2 | 0.704 | 53.6 | 21.2 |
| PN17122020_slice_106 | 0.800 | 0.160 | 0.072 | 0.802 | 158.8 | 71.0 | 0.655 | 149.4 | 64.5 | 0.703 | 53.4 | 21.2 |
| PN17122020_slice_107 | 0.807 | 0.160 | 0.072 | 0.808 | 159.0 | 71.2 | 0.665 | 149.7 | 64.9 | 0.704 | 52.4 | 20.7 |
| PN17122020_slice_108 | 0.804 | 0.164 | 0.074 | 0.806 | 163.3 | 73.6 | 0.663 | 155.0 | 67.7 | 0.698 | 52.4 | 20.8 |
| PN17122020_slice_109 | 0.800 | 0.168 | 0.076 | 0.802 | 166.8 | 74.9 | 0.659 | 159.6 | 69.3 | 0.688 | 53.0 | 21.5 |
| PN17122020_slice_110 | 0.796 | 0.171 | 0.077 | 0.797 | 170.3 | 75.7 | 0.655 | 163.8 | 70.4 | 0.680 | 55.1 | 22.5 |
| PN17122020_slice_111 | 0.789 | 0.174 | 0.077 | 0.791 | 173.2 | 76.1 | 0.650 | 165.8 | 70.2 | 0.669 | 57.8 | 24.0 |
| PN17122020_slice_112 | 0.787 | 0.176 | 0.078 | 0.788 | 175.6 | 76.8 | 0.646 | 168.1 | 70.9 | 0.661 | 59.3 | 25.0 |
| PN17122020_slice_113 | 0.787 | 0.177 | 0.078 | 0.788 | 176.1 | 77.1 | 0.643 | 167.6 | 70.7 | 0.653 | 60.1 | 25.5 |
| PN17122020_slice_114 | 0.782 | 0.176 | 0.077 | 0.783 | 174.9 | 76.4 | 0.636 | 166.3 | 70.3 | 0.649 | 62.2 | 26.8 |
| PN17122020_slice_115 | 0.779 | 0.176 | 0.078 | 0.780 | 174.8 | 76.8 | 0.630 | 166.0 | 70.5 | 0.641 | 62.7 | 27.4 |
| PN17122020_slice_116 | 0.781 | 0.174 | 0.077 | 0.783 | 173.4 | 76.3 | 0.632 | 165.2 | 70.2 | 0.636 | 62.4 | 27.4 |
| PN17122020_slice_117 | 0.787 | 0.172 | 0.076 | 0.789 | 171.4 | 75.3 | 0.634 | 164.3 | 69.8 | 0.633 | 61.5 | 27.2 |
| PN17122020_slice_118 | 0.791 | 0.171 | 0.075 | 0.792 | 170.2 | 74.2 | 0.636 | 164.1 | 69.3 | 0.630 | 60.6 | 27.0 |
| PN17122020_slice_119 | 0.790 | 0.173 | 0.076 | 0.792 | 171.6 | 74.9 | 0.637 | 165.2 | 69.6 | 0.625 | 60.6 | 27.4 |
| PN17122020_slice_120 | 0.790 | 0.173 | 0.076 | 0.792 | 172.2 | 75.1 | 0.638 | 165.7 | 69.8 | 0.623 | 60.9 | 27.9 |
| PN17122020_slice_121 | 0.791 | 0.175 | 0.077 | 0.793 | 173.8 | 75.5 | 0.637 | 167.0 | 70.2 | 0.618 | 60.8 | 27.9 |
| PN17122020_slice_122 | 0.794 | 0.174 | 0.076 | 0.796 | 172.3 | 74.7 | 0.637 | 167.3 | 70.3 | 0.615 | 60.1 | 27.4 |
| PN17122020_slice_123 | 0.796 | 0.170 | 0.075 | 0.799 | 168.8 | 73.2 | 0.638 | 164.6 | 69.3 | 0.616 | 59.9 | 27.4 |
| PN17122020_slice_124 | 0.797 | 0.167 | 0.073 | 0.799 | 165.6 | 71.5 | 0.639 | 161.8 | 67.9 | 0.615 | 60.5 | 28.1 |
| PN17122020_slice_125 | 0.799 | 0.164 | 0.072 | 0.801 | 163.2 | 70.5 | 0.642 | 159.5 | 66.8 | 0.614 | 60.2 | 28.2 |
| PN17122020_slice_126 | 0.795 | 0.164 | 0.071 | 0.798 | 162.5 | 70.0 | 0.640 | 157.8 | 65.8 | 0.611 | 60.9 | 28.7 |
| PN17122020_slice_127 | 0.796 | 0.163 | 0.071 | 0.798 | 161.8 | 69.9 | 0.640 | 156.9 | 65.5 | 0.612 | 60.9 | 28.7 |
| PN17122020_slice_128 | 0.800 | 0.161 | 0.071 | 0.802 | 160.2 | 69.5 | 0.646 | 154.7 | 64.9 | 0.613 | 60.6 | 28.6 |
| PN17122020_slice_129 | 0.797 | 0.159 | 0.071 | 0.799 | 158.4 | 69.5 | 0.642 | 152.0 | 64.5 | 0.609 | 61.6 | 29.3 |
| PN17122020_slice_130 | 0.792 | 0.158 | 0.071 | 0.794 | 156.5 | 69.9 | 0.633 | 150.2 | 65.0 | 0.603 | 62.0 | 30.0 |
| PN17122020_slice_131 | 0.803 | 0.154 | 0.069 | 0.805 | 152.5 | 67.6 | 0.647 | 146.5 | 63.1 | 0.607 | 59.2 | 28.6 |
| PN17122020_slice_132 | 0.815 | 0.148 | 0.067 | 0.817 | 147.3 | 65.1 | 0.655 | 141.6 | 60.9 | 0.607 | 56.9 | 27.2 |
| PN17122020_slice_133 | 0.819 | 0.143 | 0.064 | 0.822 | 141.7 | 62.4 | 0.657 | 136.4 | 58.5 | 0.606 | 56.2 | 26.9 |
| PN17122020_slice_134 | 0.819 | 0.139 | 0.062 | 0.821 | 138.5 | 61.0 | 0.661 | 132.0 | 56.3 | 0.607 | 56.5 | 27.4 |
| PN17122020_slice_135 | 0.819 | 0.139 | 0.062 | 0.820 | 138.4 | 60.7 | 0.661 | 131.5 | 55.8 | 0.606 | 56.2 | 27.4 |
| PN17122020_slice_136 | 0.819 | 0.140 | 0.061 | 0.820 | 139.8 | 60.4 | 0.660 | 132.3 | 55.6 | 0.606 | 56.1 | 27.5 |
| PN17122020_slice_137 | 0.823 | 0.138 | 0.060 | 0.824 | 137.6 | 58.8 | 0.666 | 131.1 | 54.4 | 0.608 | 55.6 | 27.2 |
| PN17122020_slice_138 | 0.827 | 0.133 | 0.057 | 0.828 | 132.8 | 56.9 | 0.669 | 126.8 | 52.7 | 0.610 | 54.9 | 26.8 |
| PN17122020_slice_139 | 0.828 | 0.127 | 0.056 | 0.829 | 126.3 | 55.5 | 0.669 | 120.1 | 51.3 | 0.610 | 54.8 | 26.7 |
| PN17122020_slice_140 | 0.831 | 0.119 | 0.054 | 0.832 | 118.3 | 53.4 | 0.672 | 112.1 | 49.3 | 0.613 | 54.4 | 26.6 |
| PN17122020_slice_141 | 0.833 | 0.113 | 0.053 | 0.835 | 112.2 | 52.0 | 0.671 | 105.1 | 47.8 | 0.612 | 53.9 | 26.4 |
| PN17122020_slice_142 | 0.834 | 0.108 | 0.051 | 0.836 | 106.9 | 50.7 | 0.673 | 98.5 | 46.3 | 0.612 | 53.4 | 26.2 |
| PN17122020_slice_143 | 0.835 | 0.102 | 0.050 | 0.836 | 101.5 | 49.2 | 0.677 | 93.4 | 44.8 | 0.615 | 52.9 | 25.9 |
| PN17122020_slice_144 | 0.832 | 0.098 | 0.049 | 0.833 | 97.6 | 48.1 | 0.678 | 88.8 | 43.7 | 0.618 | 54.2 | 26.2 |
| PN17122020_slice_145 | 0.825 | 0.098 | 0.049 | 0.826 | 97.9 | 48.7 | 0.673 | 88.4 | 44.2 | 0.618 | 56.2 | 27.2 |
| PN17122020_slice_146 | 0.827 | 0.098 | 0.049 | 0.828 | 97.3 | 48.3 | 0.675 | 89.1 | 44.0 | 0.620 | 56.1 | 26.8 |
| PN17122020_slice_147 | 0.828 | 0.098 | 0.049 | 0.829 | 97.4 | 48.5 | 0.676 | 89.9 | 44.2 | 0.618 | 55.7 | 26.7 |
| PN17122020_slice_148 | 0.830 | 0.098 | 0.049 | 0.831 | 97.7 | 48.3 | 0.677 | 90.0 | 43.8 | 0.617 | 54.7 | 26.3 |
| PN17122020_slice_149 | 0.831 | 0.099 | 0.049 | 0.832 | 98.4 | 48.3 | 0.682 | 90.3 | 43.6 | 0.621 | 54.8 | 26.3 |
| PN17122020_slice_150 | 0.828 | 0.100 | 0.049 | 0.829 | 99.5 | 48.5 | 0.682 | 91.4 | 43.7 | 0.623 | 55.1 | 26.4 |
| PN17122020_slice_151 | 0.825 | 0.101 | 0.049 | 0.826 | 100.7 | 49.1 | 0.681 | 92.0 | 44.2 | 0.626 | 55.7 | 26.7 |
| PN17122020_slice_152 | 0.831 | 0.101 | 0.049 | 0.832 | 100.3 | 48.5 | 0.688 | 92.2 | 43.8 | 0.630 | 54.6 | 26.0 |
Image Grid
4×3 grid: Rows show different image types (Original NATIVE, Reconstructed NATIVE, Original VENOUS, Generated VENOUS), Columns show windowing techniques (No Window, Lung Window, Mediastinum Window)
Original NATIVE CT scan (input)
Full window (WL 1023.5, WW 4095 → Low −1024, High +3071)

Original NATIVE CT scan (input)
Lung window (WL -600, WW 1500 → Low −1350, High +150)
Original NATIVE CT scan (input)
Mediastinum window (WL 40, WW 400 → Low −160, High +240)

Reconstructed NATIVE CT scan (cycle consistency)
Full window (WL 1023.5, WW 4095 → Low −1024, High +3071)

Reconstructed NATIVE CT scan (cycle consistency)
Lung window (WL -600, WW 1500 → Low −1350, High +150)

Reconstructed NATIVE CT scan (cycle consistency)
Mediastinum window (WL 40, WW 400 → Low −160, High +240)

Original VENOUS CT scan
Full window (WL 1023.5, WW 4095 → Low −1024, High +3071)

Original VENOUS CT scan
Lung window (WL -600, WW 1500 → Low −1350, High +150)

Original VENOUS CT scan
Mediastinum window (WL 40, WW 400 → Low −160, High +240)

Generated VENOUS CT scan (A→B translation)
Full window (WL 1023.5, WW 4095 → Low −1024, High +3071)

Generated VENOUS CT scan (A→B translation)
Lung window (WL -600, WW 1500 → Low −1350, High +150)

Generated VENOUS CT scan (A→B translation)
Mediastinum window (WL 40, WW 400 → Low −160, High +240)

Windowing Parameters
- No Window: Full window (WL 1023.5, WW 4095 → Low −1024, High +3071)
- Lung Window: WL -600, WW 1500 → Low −1350, High +150 (optimal for pulmonary structures)
- Mediastinum Window: WL 40, WW 400 → Low −160, High +240 (optimal for soft tissues)